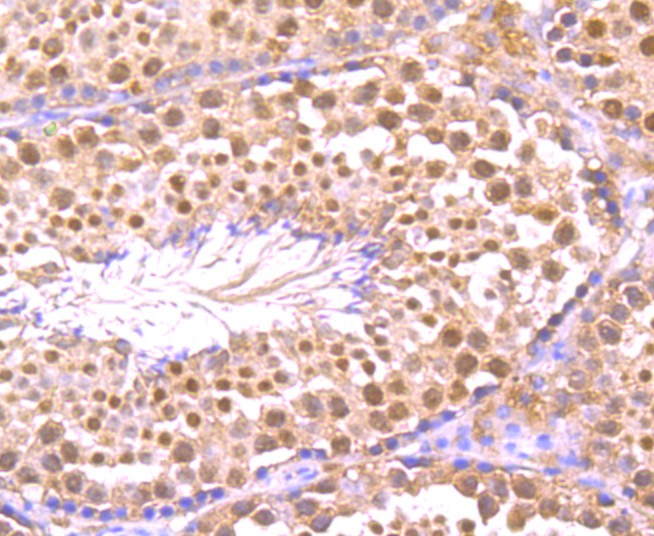

Catalog# ER1706-32
TNFAIP3 Rabbit Polyclonal Antibody
Application
-
WB
-
IF-Cell
-
IHC-P
-
FC
Reactivity
-
Human
-
Mouse
-
Rat
This product has been cited in peer reviewed publications, see list HERE